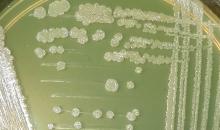
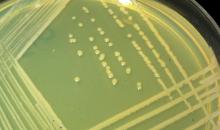

Burkholderia gladioli pv. gladioli(PSDMGD)
Photos
All photos included on this page can only be used for educational purposes.
For publication in journals, books or magazines, permission should be obtained from the original photographers with a copy to EPPO.
For publication in journals, books or magazines, permission should be obtained from the original photographers with a copy to EPPO.

Symptoms on mushroom (Agaricus bisporus) cap artificially inoculated with Burkholderia gladioli strain isolated from garlic bulb.
Courtesy: Ebrahim Osdaghi
Garlic pathogenic strains of Burkholderia gladioli infecting gladiolus corm.
Courtesy: Ebrahim Osdaghi
Colony characteristics of Burkholderia gladioli on yeast-extract peptone glucose agar (YPGA) medium: slightly wrinkled surface.
Courtesy: Ebrahim Osdaghi
Colony characteristics of Burkholderia gladioli on yeast-extract peptone glucose agar (YPGA) medium: smooth surface.
Courtesy: Ebrahim Osdaghi

